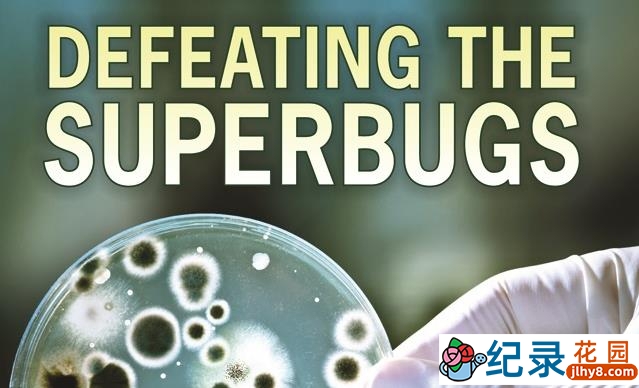
BBC防疫科普纪录片《战胜超级病菌 Defeating the Superbug》全1集 720P/1080i高清纪录片资源百度云盘下载

当前位置:
首页 >
社会科学 > BBC防疫科普纪录片《战胜超级病菌 Defeating the Superbug》全1集 720P/1080i高清纪录片资源百度云盘下载

在世界各地,我们已经看到流氓细菌的出现。 这些都是超级病菌,危险的细菌正在抵抗我们唯一的防御:抗生素。 在世界各地跟踪这些潜在杀手蔓延的科学家,研究人员正在开发击败这些超级细菌的新技术。
抗生素是人类医学史上的一大奇迹,自诞生以来拯救了无数生命。但如今,由于人们滥用抗生素、药厂随意排放污水、肉畜饲料中大量添加抗生素等问题,细菌渐渐产生了强大的抗药性,致命的“超级细菌”出现在全球各地,让医生束手无策。
面对这一紧迫问题,研究人员借助新型设备详细揭示细菌抗药性的产生过程,同时展开全面探索,在污水中、地底洞穴中、乃至奇特生物的身上寻找对抗敌人的新武器。人类与超级细菌的这场战斗正愈演愈烈。
您当前的等级为
登录后免费下载登录
小黑屋反思中,不准下载!
评论后刷新页面下载评论
支付¥以后下载
请先登录
您今天的下载次数(次)用完了,请明天再来
支付积分以后下载立即支付
支付以后下载立即支付
您当前的用户组不允许下载升级会员
您已获得下载权限
您可以每天下载资源次,今日剩余次
当前链接:https://ziyuan.yunduozy.com/98966.html
文章标题:BBC防疫科普纪录片《战胜超级病菌 Defeating the Superbug》全1集 720P/1080i高清纪录片资源百度云盘下载
文章版权:云朵资源网 (https://ziyuan.yunduozy.com) 所发布的内容,部分为原创文章,转载请注明来源,网络转载文章如有侵权请联系我们!
本文最后更新发布于:2026年01月27日 10:53,某些文章具有时效性,若有错误或已失效,请在下方留言。